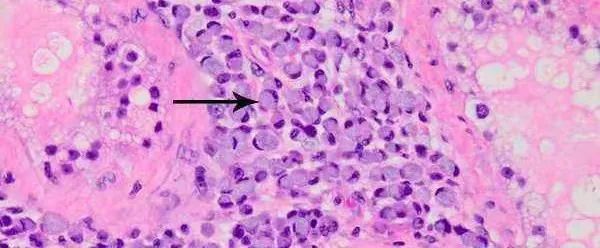

陳曉抽煙火上熱搜後,誰還記得她曾被全網刷屏惋惜…_風聞
ins生活-ins生活官方账号-生活的理想,就是理想的生活2022-06-13 08:42
作者 | 陳相忘
來源 | ins生活原創

編輯|陳相忘
又一個年輕人離開了我們。

因為癌症,她的生命將永遠定格在35歲這一年。
在最後的道別中,這位年輕的姑娘寫下兩句話:
“只恨自己命運坎坷,悲傷自己死不逢時。”
為什麼這麼説?
因為人到三十,確實有太多太多難以割捨掉的人和事:
沒能施展的抱負,對未來的期許,更重要的,還有想為爸媽養老盡孝的那一份擔當。
最後,小Q附上了自己去年手術前拍下的照片。

照片中的她,又美又颯。
其實小Q特別優秀,她年紀輕輕,就已經做到了美妝領域的百萬博主。
可惜我們大多數人都是通過「告別」這樣的方式,才第一次知道了“薄荷醬小Q”這個名字。

然而,也有網友提出了自己的疑惑:

甚至,更有人盲目猜測博主本人這麼年輕就得胃癌,是過度節食的原因:

本着“不信謠、不傳謠”的一貫宗旨,我們聯繫到了**知名健康博主@微創外科雙5槍 雙劍博博士,**來跟我們聊聊,關於癌症,你不知道的那些事兒。

小Q因患胃癌發文道別的消息一出,全網譁然。

無獨有偶,前陣子一則24歲女孩感染幽門螺旋桿菌後確診胃癌的消息,也衝上了熱搜。

除了一片心痛和震驚外,網友們如此高漲的討論度,似乎只能用四個字來形容:談“癌”色變。
那麼,我們就先來聊聊大家最關心的問題:
癌症是否真的呈現出了愈加年輕化的態勢?
在小Q的告別信中,她提到自己得的是最兇險的胃癌,也就是“印戒+低分化+瀰漫型+4期”。
這種胃癌到底有多兇險呢?
我們不妨來一一分析下。
所謂印戒細胞癌,簡單來説,就是在顯微鏡下的胃癌細胞,長得有點像一枚戒指。
這種癌的發病要相對少見,但惡性程度卻極高,患者預後也極差。
而低分化癌,則是把癌症比作壞人,分為三六九等,有的一點點壞,有的非常壞、窮兇極惡:

對於瀰漫型癌,大家就要好理解一些,指的是胃癌的腫瘤比較彌散,醫學上也稱作皮革胃。
由於這類腫瘤的體積大、發現晚,惡性程度比較高,患者治療的效果相對也會比較差。
人們常説腫瘤“早期”“晚期”,小Q提及的4期,就是腫瘤“最晚期”的意思。
也就是説,小Q之所以年紀輕輕就罹患癌症,並非網友們所揣測的那樣,是減肥或節食所致。
而是很不幸地,癌症中幾乎所有最壞的情況,都發生在了她身上。
這不禁也讓人想起同樣才華橫溢,卻因癌症早逝的“瀟灑哥”趙英俊,令人惋惜至極。

現在許多網友都很好奇,年輕人怎麼會得癌呢?
關於癌症,目前醫學上認為,主要與以下幾個方面有關:

你看,除去前兩點和未明因素,在其餘可能致癌的因素中,都和兩個字分不開干係:長期。
這也是為什麼其實癌症在老年人當中更為常見。
所以,導致像小Q這樣的年輕人患癌的主要原因,還是在於家族遺傳和先天缺陷。
但所謂遺傳,並不是説胃癌本身會遺傳,而是癌變基因會遺傳,而且還要在此基礎上,合併環境中的各種致癌因素。
比如吸煙、抑鬱情緒、幽門螺旋桿菌感染等,在經過複雜的癌變過程後,才會最終導致腫瘤發生。
不過,網友們的這一熱議,也讓我們看到,對於生活中的健康問題,人們總是容易杞人憂天:
身體有些小狀況,第一件事不是去正規醫院檢查,而是上網自查怎麼回事?
結果越查越心慌。

所以,與其自己嚇自己,不如來了解下生活裏,有哪些東西才是真正的致癌物?

可能你平時在「相親相愛一家人」羣裏,看到過這樣的好心“提醒”:
“囤貨別囤泡麪,會致癌的”
“雞精不能吃,致癌!!”
“咖啡喝多了當心會致癌”
但其中很多都是謠言,反倒是一些人們生活中經常接觸的東西,才是真正危險的致癌物。

世界衞生組織國際癌症研究機構(IARC)在2019年的專題報告中,曾提出“一類致癌物”的説法。
像我們熟悉的大氣污染、甲醛、酒精飲料、煙草、檳榔等等,就都屬於這個範疇,目前也有足夠多的證據表明,這些物質確實會導致人類患癌的風險提高。
那生活中,哪些東西是“板上釘釘”的致癌物呢?
首當其衝的致癌物,必定離不開煙酒。
這時候就有人説了:
害,那怎麼還有人抽了大半輩子煙、活到七八十歲,嘛事都沒有的呢?
説白了,這就好比是一場豪賭。
煙民下的賭注,是這把槍裏究竟有沒有子彈?可致癌物賭的,卻是半點不摻假的人命。

況且,煙民自己忍不住想來兩根華子也就算了,但身邊人如果長期和抽煙的人待在一起,也可能會引發癌症。
這不,前段時間就有一個新聞。
因為長期吸煙,男人幾年前就查出了肺癌,可沒想到,男人的妻子也不幸患上了肺癌。

這可不純粹是二手煙的鍋,還有另外一種處於人們生活知識盲區的“隱形殺手”:三手煙。
煙民在吸煙後,往往會在衣服、牆壁等表面附着有煙草殘留物。
大家可別小瞧這些殘留物,它們甚至來得比香水還持久,幾個星期內都難以去掉。
妥妥上演現實版《錯位時空》:
“我抽過你抽過的香煙,那我們算不算相擁。”
而這也是公共場所要禁止吸煙的原因。
這幾天大火的《夢華錄》,大家都看了嗎?
在放出的花絮中,由於陳曉本人抽煙的模樣實在太帥,更是直接衝上了熱搜。

但煙民朋友務必先要認清一個事實,你我可不是陳曉

,小盆友更不能去模仿哦!
所以,權當是為了家人們的身體健康,拜託各位吸煙的朋友們,事不宜遲,一定要儘早戒煙吶。
當然,除煙酒外,生活中還有一些東西我們經常會吃,卻不以為然。
比如,烤五花、紅柳木炭烤羊肉串、廣式燒臘等加工後的肉類製品,或炭烤、熏製過的食物。
媽耶,這下徹底哭惹,沒有烤肉的夏天,豈不是連靈魂都沒得了?

莫慌莫慌,不管哪種致癌物,都不會肯定致癌。
不過,我們還是應該正確看待致癌物對人身體的影響。
畢竟,知己知彼,總好過“病急亂投醫”,對吧?
一般呢,肉類製品在經過加工後,會含有過量的亞硝酸鹽,它們和胃裏的蛋白分解物會合成出一種叫做亞硝胺的致癌物,從而增加患胃癌和食道癌的風險。
而燒烤的時候,由於脂肪融化後滴在炭火上不完全燃燒,也會產生大量的致癌物苯並芘,人們吃多了就可能會患上肝癌和肺癌。
其實我們還是要儘量改掉愛吃高鹽食物的飲食習慣,多吃新鮮的水果蔬菜才好。
咳咳,説到這就要劃重點了!吃水果蔬菜一定要保證新鮮!
之前就有新聞報道了一對開水果店的夫妻:
因不捨得丟棄掉當天店裏沒能賣完的水果,就剜掉壞的部分再吃,卻沒想到,兩人都被查出了肝癌。

這是因為水果在發黴、變質後,可能會含有一種叫做黃麴黴毒素的致癌物。
此外它還會擴散,哪怕我們肉眼看上去,其他地方一點問題沒有,但可能也早就被污染了。
所以,只要發現食物發黴了,果斷説拜拜就對了,保證下一個會更香甜!


聊到這,其實生活中還有很多致癌物,不誇張地説,甚至列舉個三天三夜都説不完。
但我們並不想渲染所謂的「健康焦慮」,什麼這也不能吃,那也不得行,最後只好來一句“毀滅吧,趕緊的,累了”。

我們的初衷,是想為大家科普一下癌症的基本發病原理,並能夠引導大家正確去看待致癌物可能引發的危害。
不要因為哪天突然蹦出來個與癌症有關的熱搜,就立馬亂了陣腳,陷入無意義的恐慌當中。
在此基礎上,更重要的是,我們還想帶給大家一種切實可行的健康理念與方式~
比方説,不久前,演員何潤東就在網上發佈了一條與自己健身有關的視頻。
視頻中,何潤東本人正面回應了網友們紛紛調侃他健壯地像極了一個表情包

:

但“步驚雲”也連忙擺手稱,自己比起劉畊宏男孩,那還是差遠了。
看看這健碩的胸肌,確定不是在凡爾賽嗎?(沒有不相信何老師只是謙遜的意思。
當然,他也坦白説,自己偶爾也會荒廢,打打遊戲、喝點小酒啥的,算是一種擺爛式健身,主要是為了取得自己在生活與健身之間的一個平衡。
同時,他也聊到很多人講“喝酒不好”:

邏輯鬼才何老師
於是呢,何潤東老師補充説,如果有時候跟朋友出去,多喝了幾杯的話,隔天他就會儘可能多練一點,用這樣的方式再把它給補回來。

説到做到
其實,這就是一種很好地看待生活習慣的態度呀,不是嗎?

小天后鄧紫棋也經歷過同樣的困擾。
因為被網友攻擊身材,陷入懷疑的她,甚至三天都不吃東西只喝水,這也直接導致她的身體和情緒,都逐漸失衡了。
後來,意識到要正確減肥的她,成功瘦身,還在網上和大家分享了自己的小秘訣。
比如,有人會説喝咖啡不好,但鄧紫棋早餐前都會先喝一杯咖啡,不僅能提神,還能加速新城代謝去水腫,只是要注意不能喝三合一之類的咖啡,而是黑咖啡,熱量也更低。

所以只要我們能保證合理的飲食,少油少鹽少糖且營養豐富,就是最健康的!
我們每個人都有不同的生活習慣和方式,其中自然有好也有壞,這就需要我們學會去用更加理性、科學的眼光看待它。
例如之前有個報道説,辣椒素不僅能抑制幽門螺旋桿菌生長,甚至還有減肥的效果。

一聽這個,很多人難免會片面地認為:
那我多吃點辣椒不就完了?還擔心什麼幽門螺旋桿菌感染
但辣椒和辣椒素壓根不是一個意思,對腸胃不太好的朋友來説,辣椒吃多了還容易刺激腸胃。

所以,我們才要學會用辯證地眼光去看待那些生活中有關健康的小tips。
就像何潤東老師所説,儘可能去找到生活與健康之間的那個平衡點,就已足夠。
